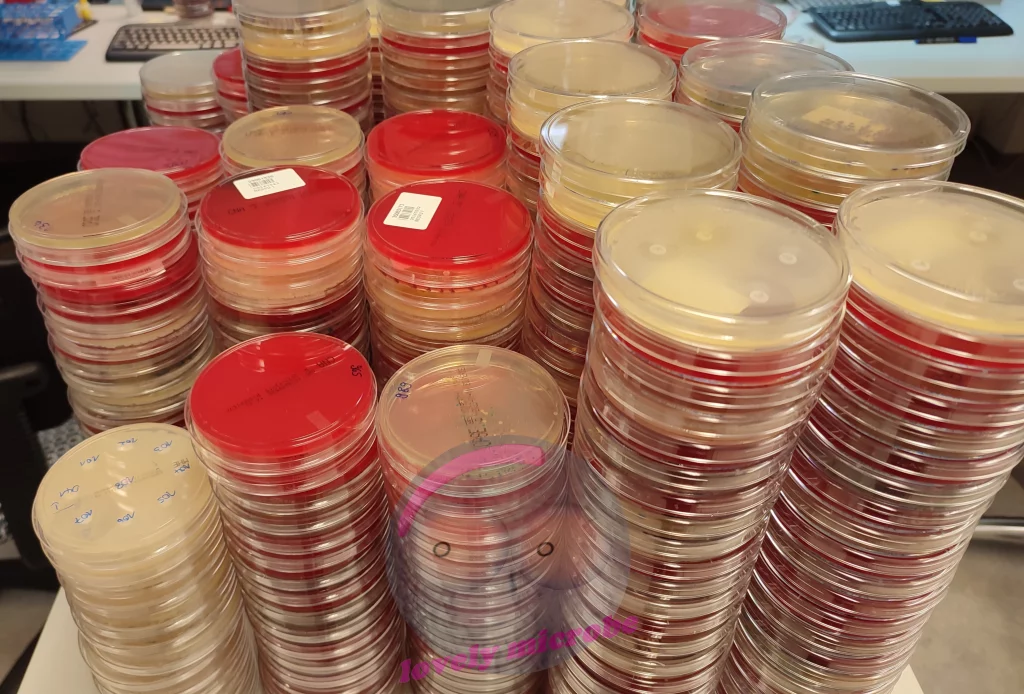
Agar Platten im Labor

XLD Agar in der Stuhldiagnostik leicht erklärt
XLD Agar in der Stuhldiagnostik leicht erklärt Der XLD (Xylose-Lysin-Desoxycholat) Agar gehört zum Standardrepertoire in der Stuhldiagnostik. Einführung:Mikrobiologie leicht erklärt: Nährmedien, ihre Typen und Anwendungen Blutagar einfach erklärt – Aufbau, Hämolyse und Anwendung MacConkey Agar erklärt: Selektiv- und Differentialmedium für gramnegative Bakterien Kochblutagar einfach erklärt: Optimalmedien für anspruchsvolle Erreger CLED Agar in der Urindiagnostik einfach […]
XLD Agar in der Stuhldiagnostik leicht erklärt Read More »